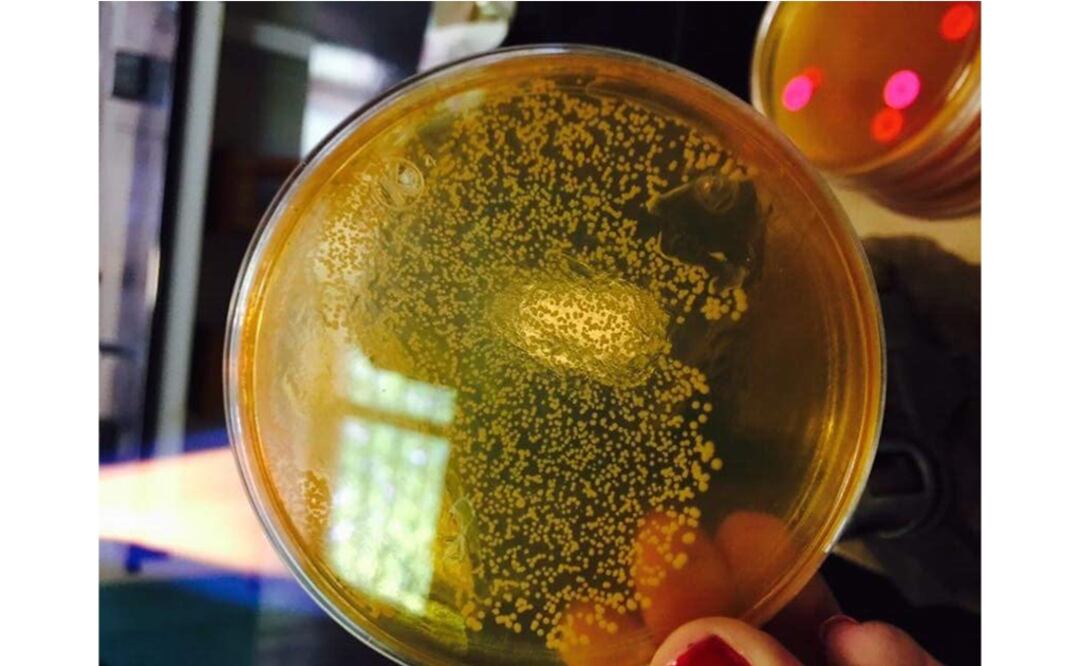
The gummy will help prevent some oral diseases by inhibiting bacteria – Photo: Courtesy of CONACYT

Scientists from the Chemistry Department of the Autonomous University of Coahuila are developing a jelly candy based on medicinal plants to treat periodontal (gum) diseases and cavities .
The gummy itself is made of natural extracts, sugar-free but with a sweet flavor, which will help prevent some oral diseases by inhibiting the bacteria which cause them, according to researcher Elizabeth Vargas.
The purpose of the research, of which Anna Ilina and Patricia Ceniceros are also members, is to test different methods to extract the bio-active components of 15 medicinal plants.
“Thus far, food to treat periodontal diseases has never been developed in Mexico. There are prior researches on plant extracts but these have never been added to food so I think this will be our contribution,” said Vargas.
“We have two years and a half with this research and the food itself has been tested on patients, and we've found bacteria have decreased, on average, between 30 to 50 percent,” she added.
According to the researcher, this product has a practical application potential and can be adapted for other pharmaceutical uses by modifying the composition of the jelly.
The research team is still working on identifying other bacteria the extracts may have an effect on and on concluding the patent process of their investigation.

(Gummies made of medicinal plant extracts - Photo: Courtesy of CONACYT)
am
Noticias según tus intereses
[Publicidad]
[Publicidad]